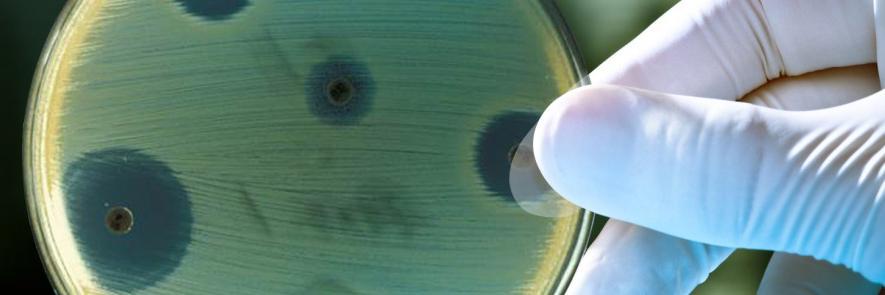
DRIVE-AB banner

'Vaccine uptake among children in England has fallen since start of pandemic.' Bad news for #AMR? theguardian.com/society/2023/a…
English
DRIVE-AB
608 posts

I've posted my slide summary of DRIVE-AB's 4 recommended incentives: grants, pipeline coordination, MERs, continuity amr.solutions/blog/summary-o…


How should a market entry reward for new antibiotics look like? David Findlay @GSK presents the recommendations from @DRIVE_AB. #DRIVEAB2017












